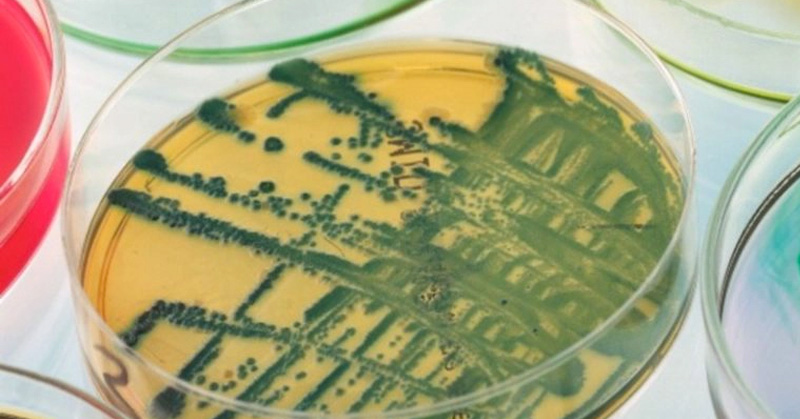

VIDEO: Policía se mete a auto destruido para salvar a un niño

l pequeño estaba atado a un asiento de seguridad, y los agentes notaron que el color de sus piernas estaba cambiando
No tienen dinero para un celular

En colonias populares menores padecen para tomar sus clases
Será 2021 un año de recortes

Admite titular de Dirección de Economía.
Fallece Wanda Seux, vedette y actriz mexico-paraguaya

La bailarina perdió la vida a los 72 años de edad
Vandalizan alumbrado en Miramar

Generan maleantes condiciones para perpetrar asaltos.
Dejan sin efectos prohibición para transmitir las ‘mañaneras’

Quedó sin efectos la prohibición del INE a concesionarios de radio y televisión de Hidalgo y Coahuila de transmitir íntegras las conferencias matutinas del presidente López Obrador
Mujer asesinó a su amiga embarazada para robar su bebé

La policía de Canelinha, Brasil detuvo a una pareja por el asesinato de una mujer embarazada y pretendían quedarse con el bebé
Bacteria mata 4 bebés y daña a 96 en Italia
Según los primeros reportes, esta bacteria se encontraba en unos de los grifos de agua que se ocupaban para limpiar biberones en la unidad de cuidados intensivos del hospital ubicado al norte de Italia.
PRI logra Mayoría Calificada de la Cámara de Diputados

Dulce María Sauri Riancho presidirá la Mesa Directiva para el Tercer Año de Ejercicio de la 64 Legislatura en la Cámara de Diputados
Confirma Lalo Mora Jr que su padre se encuentra estable

En la reciente actualización de este miércoles sobre la salud de El Rey de Mil Coronas, su hijo revela avance positivo en la salud del cantante